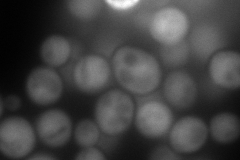
YDL110C
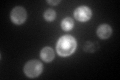
YDL110C

View description
Protein of unknown function that associates with ribosomes; heterozygous deletion demonstrated increases in chromosome instability in a rad9 deletion background; protein abundance is decreased upon intracellular iron depletion
Localization:
Intensity:
Fold change:
Significance:
-
C’ GFP library in SD

cytosol72.8 -
N' NOP1pr-GFP in SD

cytosol157.897 -
N' TEF2pr-mCherry in SD
cytosol271.908 -
N' NATIVEpr-GFP in SD

cytosol24.3524 -
N' TEF2pr-VC and Cyto-VN in SD

#N/A0 -
C’ GFP library in SD+DTT

cytosol141.711.94Yes -
C’ GFP library in SD+H2O2

cytosol90.111.23No -
C’ GFP library in Starvation Media
nucleusN/AN/AYes -
C’ GFP library on the background of Pup2-DaMP

cytosol -
C’ GFP library on the background of CCT mutant

cytosol63.20020.868003No
